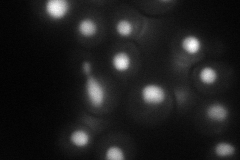
YPL038W
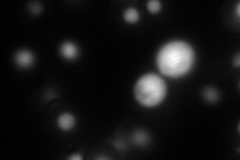
YPL038W
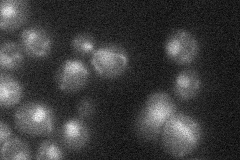
YPL038W
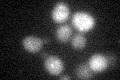
YPL038W

View description
Zinc-finger DNA-binding protein, involved in transcriptional regulation of the methionine biosynthetic genes, similar to Met32p
Localization:
Intensity:
Fold change:
Significance:
-
C’ GFP library in SD

below threshold15.52 -
N' NOP1pr-GFP in SD
nucleus69.748 -
N' TEF2pr-mCherry in SD
nucleus72.6489 -
N' NATIVEpr-GFP in SD
nucleus21.7368 -
N' TEF2pr-VC and Cyto-VN in SD

nucleus27.1196 -
C’ GFP library in SD+DTT
cytosol14.640.94No -
C’ GFP library in SD+H2O2

cytosol15.851.02No -
C’ GFP library in Starvation Media

cytosol15.350.98No -
C’ GFP library on the background of Pup2-DaMP

below threshold -
C’ GFP library on the background of CCT mutant

below threshold16.54591.06522No
